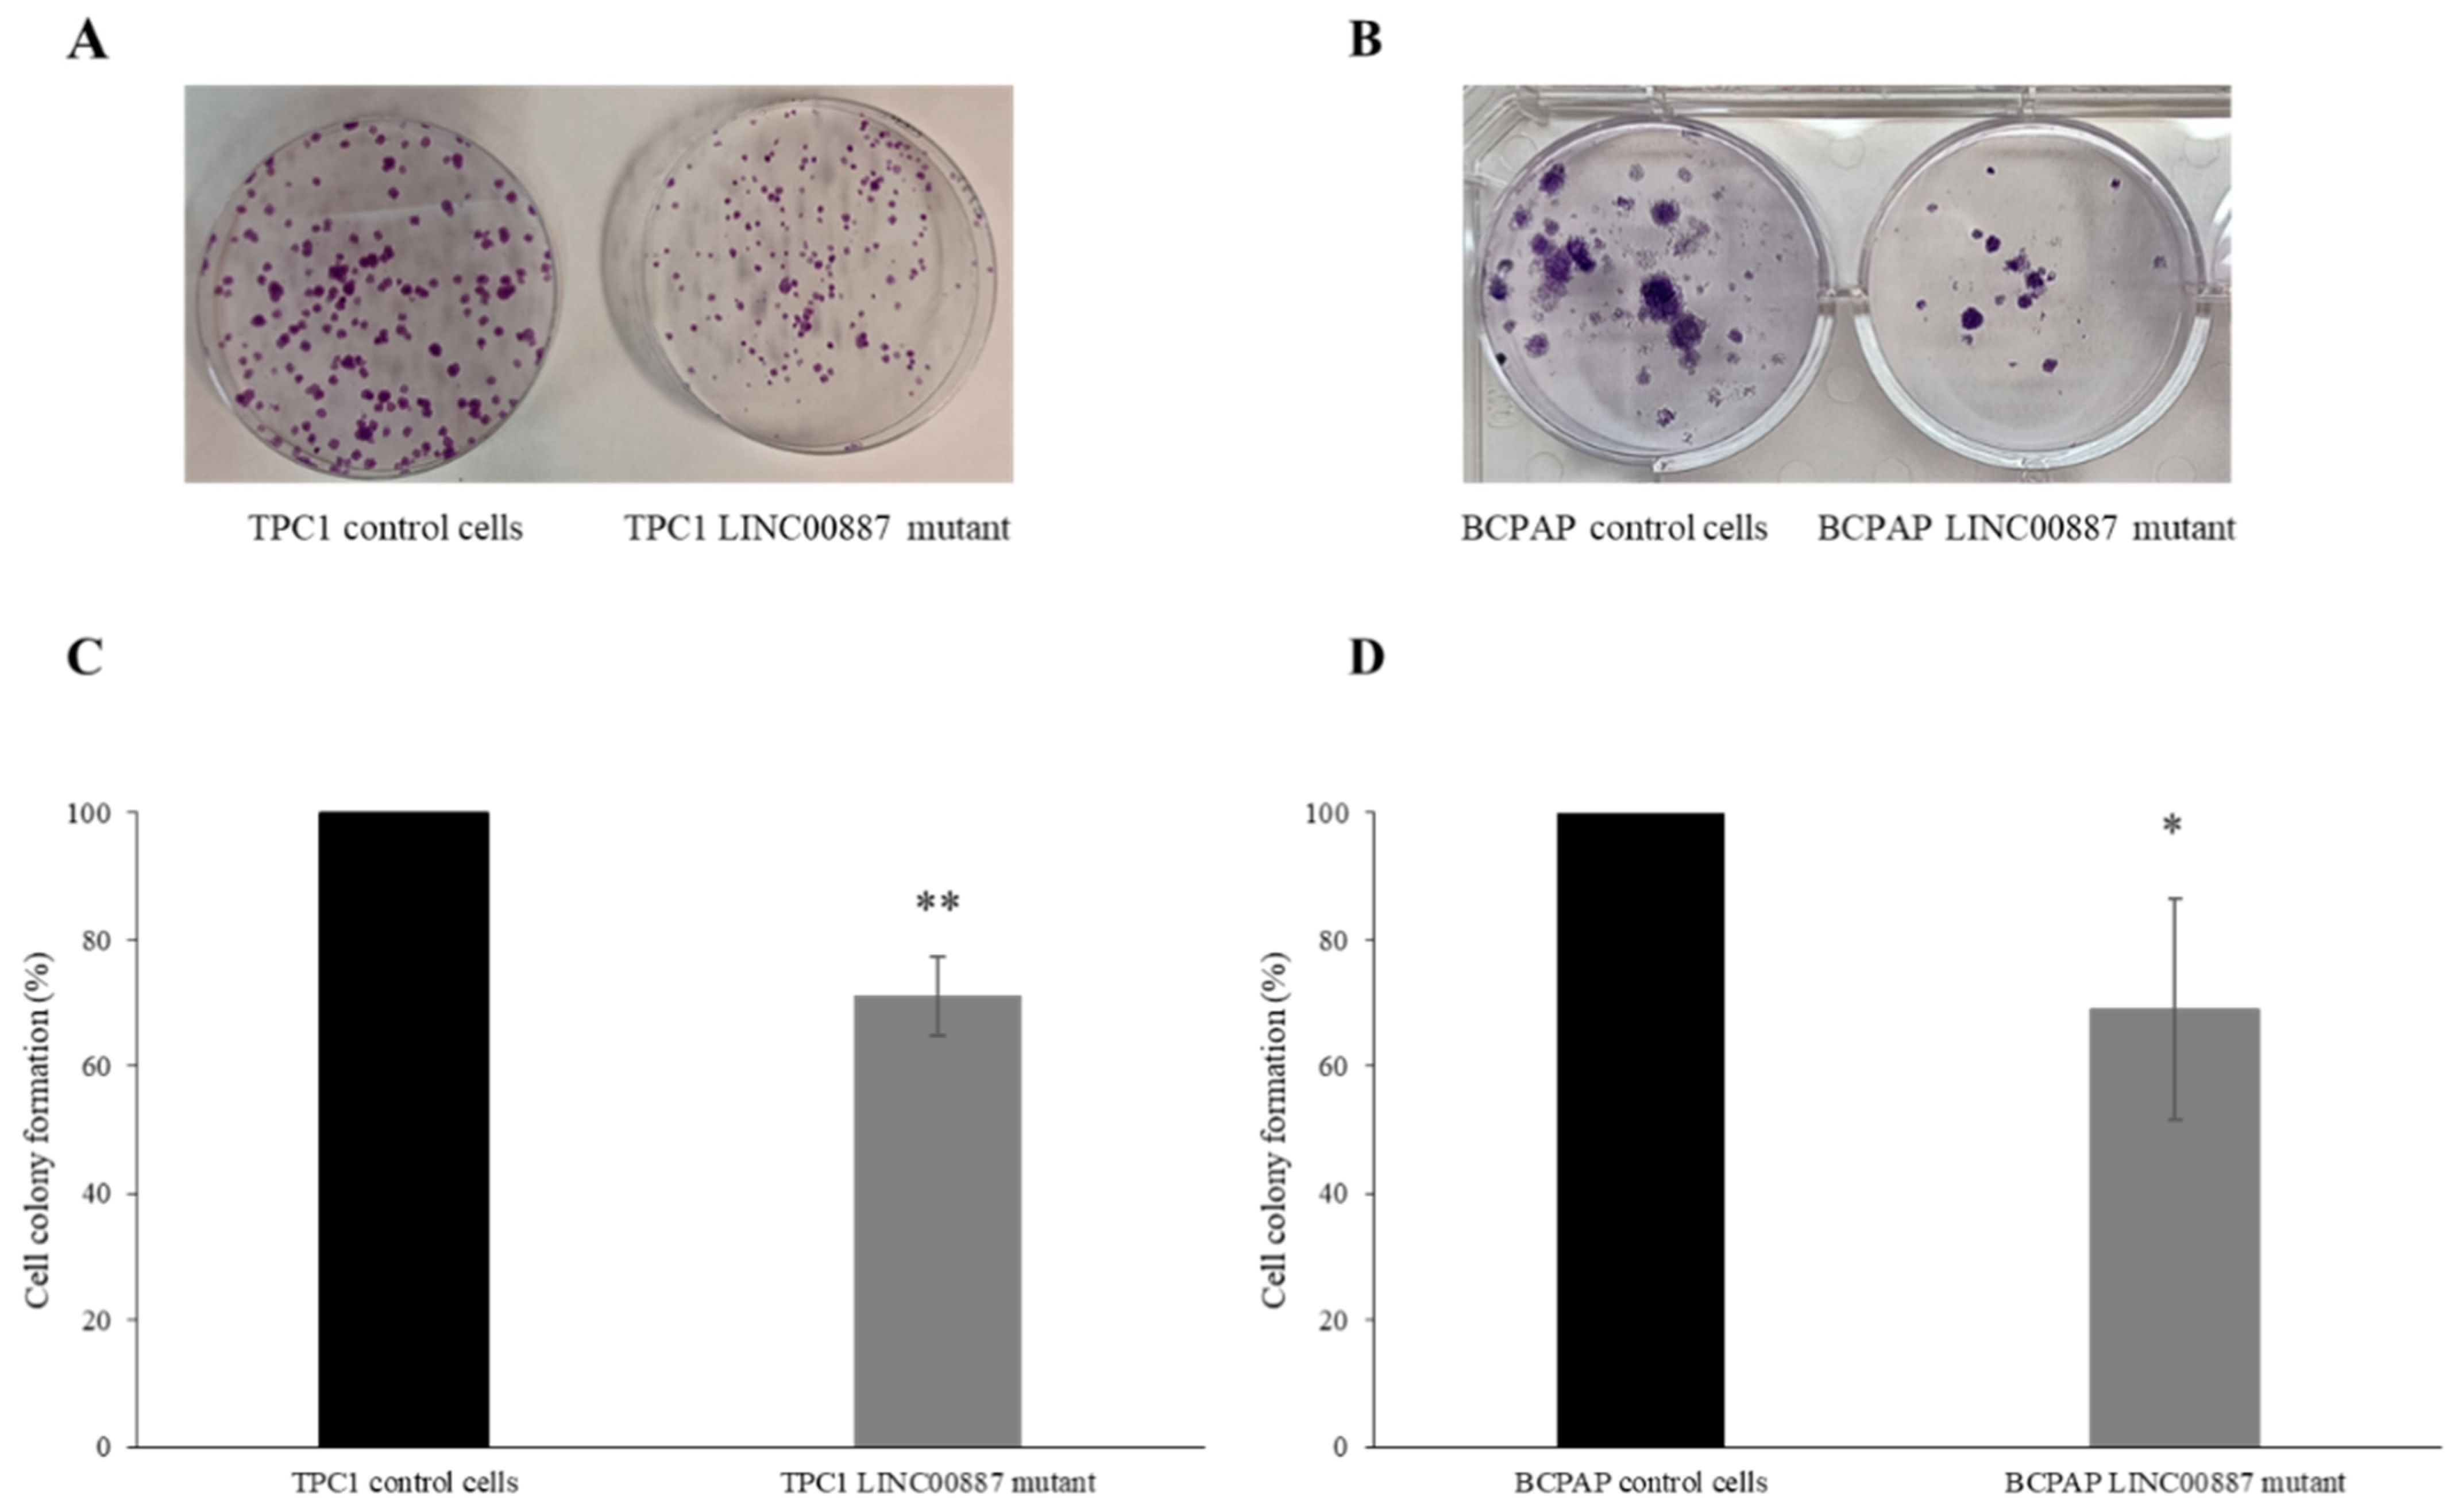
Ijms 25 01587 g004

Delving into the Role of lncRNAs in Papillary Thyroid Cancer: Upregulation of LINC00887 Promotes Cell Proliferation, Growth and Invasion
Abstract
1. Introduction
2. Results
2.1. Isoform Detection and In Vivo Truncation of LINC00887 via Genome Editing
2.2. Expression of LINC00887 in Papillary Thyroid Cancer
2.3. The Role of LINC00887 in Cell Proliferation and Colony Formation
2.4. LINC00887 Knockdown Disrupted Cell Migration and Invasion
2.5. Effect on Cell Cycle and Apoptosis by LINC00887
2.6. LINC00887 Promotes PD-L1 Downregulation
2.7. In Silico Prediction Secondary Structure of LINC00887 Mutants Differed Significantly from Control Cells
3. Discussion
4. Materials and Methods
4.1. Cell Culture
4.2. CRISPR/Cas9 Genomic Editing
4.3. Genotyping and Isoform Detection by Sanger Sequencing
4.4. RNA Extraction and Quantitative Real-Time PCR (qRT-PCR)
4.5. Cell Proliferation Assay
4.6. Colony Formation Assay
4.7. Wound Healing Assay
4.8. Cell Cycle Assay
4.9. Apoptosis Assay
4.10. Western Blotting
4.11. In Silico Prediction of the Secondary Structure
4.12. Statistical Analysis
Supplementary Materials
Author Contributions
Funding
Institutional Review Board Statement
Informed Consent Statement
Data Availability Statement
Conflicts of Interest
References
- Bogovic Crncic, T.; Ilic Tomas, M.; Girotto, N.; Grbac Ivankovic, S. Risk Factors for Thyroid Cancer: What Do We Know So Far? Acta Clin. Croat. 2020, 59 (Suppl. 1), 66–72. [Google Scholar] [CrossRef] [PubMed]
- Siegel, R.L.; Miller, K.D.; Jemal, A. Cancer Statistics, 2017. CA Cancer J. Clin. 2017, 67, 7–30. [Google Scholar] [CrossRef] [PubMed]
- Luzon-Toro, B.; Fernandez, R.M.; Martos-Martinez, J.M.; Rubio-Manzanares-Dorado, M.; Antinolo, G.; Borrego, S. LncRNA LUCAT1 as a novel prognostic biomarker for patients with papillary thyroid cancer. Sci. Rep. 2019, 9, 14374. [Google Scholar] [CrossRef] [PubMed]
- Du, Z.; Wang, B.; Tan, F.; Wu, Y.; Chen, J.; Zhao, F.; Liu, M.; Zhou, G.; Yuan, C. The regulatory role of LncRNA HCG18 in various cancers. J. Mol. Med. 2023, 101, 351–360. [Google Scholar] [CrossRef] [PubMed]
- Jendrzejewski, J.; Thomas, A.; Liyanarachchi, S.; Eiterman, A.; Tomsic, J.; He, H.; Radomska, H.S.; Li, W.; Nagy, R.; Sworczak, K.; et al. PTCSC3 Is Involved in Papillary Thyroid Carcinoma Development by Modulating S100A4 Gene Expression. J. Clin. Endocrinol. Metab. 2015, 100, E1370–E1377. [Google Scholar] [CrossRef] [PubMed]
- Yang, J.; Ma, Y.; Gong, Y.; Gong, R.; Li, Z.; Zhu, J. Multiple Simultaneous Rare Distant Metastases as the Initial Presentation of Papillary Thyroid Carcinoma: A Case Report. Front. Endocrinol. 2019, 10, 759. [Google Scholar] [CrossRef]
- Xing, M. Molecular pathogenesis and mechanisms of thyroid cancer. Nat. Rev. Cancer 2013, 13, 184–199. [Google Scholar] [CrossRef]
- Cai, W.Y.; Chen, X.; Chen, L.P.; Li, Q.; Du, X.J.; Zhou, Y.Y. Role of differentially expressed genes and long non-coding RNAs in papillary thyroid carcinoma diagnosis, progression, and prognosis. J. Cell. Biochem. 2018, 119, 8249–8259. [Google Scholar] [CrossRef]
- Sui, X.; Geng, J.H.; Li, Y.H.; Zhu, G.Y.; Wang, W.H. Calcium channel alpha2delta1 subunit (CACNA2D1) enhances radioresistance in cancer stem-like cells in non-small cell lung cancer cell lines. Cancer Manag. Res. 2018, 10, 5009–5018. [Google Scholar] [CrossRef]
- Huarte, M. The emerging role of lncRNAs in cancer. Nat. Med. 2015, 21, 1253–1261. [Google Scholar] [CrossRef] [PubMed]
- Ge, W.J.; Huang, H.; Wang, T.; Zeng, W.H.; Guo, M.; Ren, C.R.; Fan, T.Y.; Liu, F.; Zeng, X. Long non-coding RNAs in hepatocellular carcinoma. Pathol. Res. Pract. 2023, 248, 154604. [Google Scholar] [CrossRef]
- Li, C.H.; Chen, Y. Targeting long non-coding RNAs in cancers: Progress and prospects. Int. J. Biochem. Cell Biol. 2013, 45, 1895–1910. [Google Scholar] [CrossRef]
- Xing, C.; Sun, S.G.; Yue, Z.Q.; Bai, F. Role of lncRNA LUCAT1 in cancer. Biomed. Pharmacother. 2021, 134, 111158. [Google Scholar] [CrossRef]
- Vecera, M.; Sana, J.; Lipina, R.; Smrcka, M.; Slaby, O. Long Non-Coding RNAs in Gliomas: From Molecular Pathology to Diagnostic Biomarkers and Therapeutic Targets. Int. J. Mol. Sci. 2018, 19, 2754. [Google Scholar] [CrossRef] [PubMed]
- Gao, P.; Jiao, H.; Zhe, L.; Cui, J. High expression of LINC0163 promotes progression of papillary thyroid cancer by regulating epithelial-mesenchymal transition MITF. Eur. Rev. Med. Pharmacol. Sci. 2020, 24, 5504–5511. [Google Scholar] [CrossRef] [PubMed]
- Di, W.; Li, Q.; Shen, W.; Guo, H.; Zhao, S. The long non-coding RNA HOTAIR promotes thyroid cancer cell growth, invasion and migration through the miR-1-CCND2 axis. Am. J. Cancer Res. 2017, 7, 1298–1309. [Google Scholar] [PubMed]
- Wu, L.; Shi, Y.; Liu, B.; Zhao, M. Expression of lncRNA-HOTAIR in the serum of patients with lymph node metastasis of papillary thyroid carcinoma and its impact. Oncol. Lett. 2020, 20, 907–913. [Google Scholar] [CrossRef] [PubMed]
- Lv, P.; Xue, Y. ETS like-1 protein ELK1-induced lncRNA LINC01638 accelerates the progression of papillary thyroid cancer by regulating Axin2 through Wnt/beta-catenin signaling pathway. Bioengineered 2021, 12, 3873–3885. [Google Scholar] [CrossRef] [PubMed]
- Lin, J.; Zhang, X.; Xue, C.; Zhang, H.; Shashaty, M.G.; Gosai, S.J.; Meyer, N.; Grazioli, A.; Hinkle, C.; Caughey, J.; et al. The long noncoding RNA landscape in hypoxic and inflammatory renal epithelial injury. Am. J. Physiol. Renal Physiol. 2015, 309, F901–F913. [Google Scholar] [CrossRef] [PubMed]
- Wu, J.; Lin, R.; Zhang, L.; Wei, Y.; Zhang, R.; Cai, W.; Hu, W. LINC00887 Fosters Development of Clear Cell Renal Cell Carcinoma via Inhibiting CD8+ T Cell Immune Infiltration. Comput. Math. Methods Med. 2022, 2022, 2582474. [Google Scholar] [CrossRef]
- Xie, J.; Zhong, Y.; Chen, R.; Li, G.; Luo, Y.; Yang, J.; Sun, Z.; Liu, Y.; Liu, P.; Wang, N.; et al. Serum long non-coding RNA LINC00887 as a potential biomarker for diagnosis of renal cell carcinoma. FEBS Open Bio 2020, 10, 1802–1809. [Google Scholar] [CrossRef]
- Xiong, J.; Liu, Y.; Luo, S.; Jiang, L.; Zeng, Y.; Chen, Z.; Shi, X.; Lv, B.; Tang, W. High expression of the long non-coding RNA HEIRCC promotes Renal Cell Carcinoma metastasis by inducing epithelial-mesenchymal transition. Oncotarget 2017, 8, 6555–6563. [Google Scholar] [CrossRef] [PubMed]
- Yue, W.J.; Wang, Y.; Li, W.Y.; Wang, Z.D. LINC00887 regulates the proliferation of nasopharyngeal carcinoma via targeting miRNA-203b-3p to upregulate NUP205. Eur. Rev. Med. Pharmacol. Sci. 2020, 24, 8863–8870. [Google Scholar] [CrossRef] [PubMed]
- Shen, X.M.; Han, S.; Liu, N.; Xu, H.Q.; Yan, C.X.; Yu, C.J. LINC00887 aggravates the malignant progression of glioma via upregulating CCND1. Eur. Rev. Med. Pharmacol. Sci. 2021, 25, 1928–1935. [Google Scholar] [CrossRef] [PubMed]
- Xu, L.B.; Bo, B.X.; Xiong, J.; Ren, Y.J.; Han, D.; Wei, S.H.; Ren, X.P. Long non-coding RNA LINC00887 promotes progression of lung carcinoma by targeting the microRNA-206/NRP1 axis. Oncol. Lett. 2021, 21, 87. [Google Scholar] [CrossRef] [PubMed]
- Shen, T.; Xia, W.; Min, S.; Yang, Z.; Cheng, L.; Wang, W.; Zhan, Q.; Shao, F.; Zhang, X.; Wang, Z.; et al. A pair of long intergenic non-coding RNA LINC00887 variants act antagonistically to control Carbonic Anhydrase IX transcription upon hypoxia in tongue squamous carcinoma progression. BMC Biol. 2021, 19, 192. [Google Scholar] [CrossRef] [PubMed]
- Li, P.; Wang, J.; Zhi, L.; Cai, F. Linc00887 suppresses tumorigenesis of cervical cancer through regulating the miR-454-3p/FRMD6-Hippo axis. Cancer Cell Int. 2021, 21, 33. [Google Scholar] [CrossRef] [PubMed]
- Ghafouri-Fard, S.; Shoorei, H.; Hussen, B.M.; Poornajaf, Y.; Taheri, M.; Sharifi, G. Interplay between programmed death-ligand 1 and non-coding RNAs. Front. Immunol. 2022, 13, 982902. [Google Scholar] [CrossRef] [PubMed]
- Sultmann, H.; Diederichs, S. Long noncoding RNA: “LNCs” to cancer. Eur. Urol. 2014, 65, 1152–1153. [Google Scholar] [CrossRef]
- Zhao, Y.; Wang, H.; Wu, C.; Yan, M.; Wu, H.; Wang, J.; Yang, X.; Shao, Q. Construction and investigation of lncRNA-associated ceRNA regulatory network in papillary thyroid cancer. Oncol. Rep. 2018, 39, 1197–1206. [Google Scholar] [CrossRef]
- Renganathan, A.; Felley-Bosco, E. Long Noncoding RNAs in Cancer and Therapeutic Potential. Adv. Exp. Med. Biol. 2017, 1008, 199–222. [Google Scholar] [CrossRef]
- Lan, X.; Zhang, H.; Wang, Z.; Dong, W.; Sun, W.; Shao, L.; Zhang, T.; Zhang, D. Genome-wide analysis of long noncoding RNA expression profile in papillary thyroid carcinoma. Gene 2015, 569, 109–117. [Google Scholar] [CrossRef] [PubMed]
- Lin, R.X.; Yang, S.L.; Jia, Y.; Wu, J.C.; Xu, Z.; Zhang, H. Epigenetic regulation of papillary thyroid carcinoma by long non-coding RNAs. Semin. Cancer Biol. 2022, 83, 253–260. [Google Scholar] [CrossRef] [PubMed]
- Wang, H.; Zhang, Z.; Yan, Z.; Ma, S. PD-L1, PDK-1 and p-Akt are correlated in patients with papillary thyroid carcinoma. Adv. Clin. Exp. Med. 2020, 29, 785–792. [Google Scholar] [CrossRef] [PubMed]
- Siraj, A.K.; Parvathareddy, S.K.; Pratheeshkumar, P.; Divya, S.P.; Al-Sobhi, S.S.; Al-Dayel, F.; Al-Kuraya, K.S. PD-L1 Is an Independent Prognostic Marker in Middle Eastern PTC and Its Expression Is Upregulated by BRAFV600E Mutation. Cancers 2021, 13, 555. [Google Scholar] [CrossRef] [PubMed]
- Feng, D.; Qin, B.; Pal, K.; Sun, L.; Dutta, S.; Dong, H.; Liu, X.; Mukhopadhyay, D.; Huang, S.; Sinicrope, F.A. BRAFV600E-induced, tumor intrinsic PD-L1 can regulate chemotherapy-induced apoptosis in human colon cancer cells and in tumor xenografts. Oncogene 2019, 38, 6752–6766. [Google Scholar] [CrossRef] [PubMed]
- Girolami, I.; Pantanowitz, L.; Mete, O.; Brunelli, M.; Marletta, S.; Colato, C.; Trimboli, P.; Crescenzi, A.; Bongiovanni, M.; Barbareschi, M.; et al. Programmed Death-Ligand 1 (PD-L1) Is a Potential Biomarker of Disease-Free Survival in Papillary Thyroid Carcinoma: A Systematic Review and Meta-Analysis of PD-L1 Immunoexpression in Follicular Epithelial Derived Thyroid Carcinoma. Endocr. Pathol. 2020, 31, 291–300. [Google Scholar] [CrossRef] [PubMed]
- Ahn, S.; Kim, T.H.; Kim, S.W.; Ki, C.S.; Jang, H.W.; Kim, J.S.; Kim, J.H.; Choe, J.H.; Shin, J.H.; Hahn, S.Y.; et al. Comprehensive screening for PD-L1 expression in thyroid cancer. Endocr. Relat. Cancer 2017, 24, 97–106. [Google Scholar] [CrossRef]
- Bastman, J.J.; Serracino, H.S.; Zhu, Y.; Koenig, M.R.; Mateescu, V.; Sams, S.B.; Davies, K.D.; Raeburn, C.D.; McIntyre, R.C., Jr.; Haugen, B.R.; et al. Tumor-Infiltrating T Cells and the PD-1 Checkpoint Pathway in Advanced Differentiated and Anaplastic Thyroid Cancer. J. Clin. Endocrinol. Metab. 2016, 101, 2863–2873. [Google Scholar] [CrossRef]
- Zwaenepoel, K.; Jacobs, J.; De Meulenaere, A.; Silence, K.; Smits, E.; Siozopoulou, V.; Hauben, E.; Rolfo, C.; Rottey, S.; Pauwels, P. CD70 and PD-L1 in anaplastic thyroid cancer—Promising targets for immunotherapy. Histopathology 2017, 71, 357–365. [Google Scholar] [CrossRef]
- Ahn, J.; Jin, M.; Song, E.; Ryu, Y.M.; Song, D.E.; Kim, S.Y.; Kim, T.Y.; Kim, W.B.; Shong, Y.K.; Jeon, M.J.; et al. Immune Profiling of Advanced Thyroid Cancers Using Fluorescent Multiplex Immunohistochemistry. Thyroid 2021, 31, 61–67. [Google Scholar] [CrossRef] [PubMed]
- Chandra Gupta, S.; Nandan Tripathi, Y. Potential of long non-coding RNAs in cancer patients: From biomarkers to therapeutic targets. Int. J. Cancer 2017, 140, 1955–1967. [Google Scholar] [CrossRef] [PubMed]
- Liu, C.; Song, Y.; Li, D.; Wang, B. Regulation of the tumor immune microenvironment by the Hippo Pathway: Implications for cancer immunotherapy. Int. Immunopharmacol. 2023, 122, 110586. [Google Scholar] [CrossRef] [PubMed]
- Chandrashekar, D.S.; Bashel, B.; Balasubramanya, S.A.H.; Creighton, C.J.; Ponce-Rodriguez, I.; Chakravarthi, B.; Varambally, S. UALCAN: A Portal for Facilitating Tumor Subgroup Gene Expression and Survival Analyses. Neoplasia 2017, 19, 649–658. [Google Scholar] [CrossRef]
- Zhu, Y.; Sun, W.; Jiang, X.; Bai, R.; Luo, Y.; Gao, Y.; Li, S.; Huang, Z.; Gong, Y.; Xie, C. Differential effects of WRAP53 transcript variants on non-small cell lung cancer cell behaviors. PLoS ONE 2023, 18, e0281132. [Google Scholar] [CrossRef]
- World Medical, A. World Medical Association Declaration of Helsinki: Ethical principles for medical research involving human subjects. JAMA 2013, 310, 2191–2194. [Google Scholar] [CrossRef]

Disclaimer/Publisher’s Note: The statements, opinions and data contained in all publications are solely those of the individual author(s) and contributor(s) and not of MDPI and/or the editor(s). MDPI and/or the editor(s) disclaim responsibility for any injury to people or property resulting from any ideas, methods, instructions or products referred to in the content. |
© 2024 by the authors. Licensee MDPI, Basel, Switzerland. This article is an open access article distributed under the terms and conditions of the Creative Commons Attribution (CC BY) license (https://creativecommons.org/licenses/by/4.0/).
Share and Cite
Tous, C.; Muñoz-Redondo, C.; Gavilán, A.; Bravo-Gil, N.; Baco-Antón, F.; Navarro-González, E.; Antiñolo, G.; Borrego, S. Delving into the Role of lncRNAs in Papillary Thyroid Cancer: Upregulation of LINC00887 Promotes Cell Proliferation, Growth and Invasion. Int. J. Mol. Sci. 2024, 25, 1587. https://doi.org/10.3390/ijms25031587
Tous C, Muñoz-Redondo C, Gavilán A, Bravo-Gil N, Baco-Antón F, Navarro-González E, Antiñolo G, Borrego S. Delving into the Role of lncRNAs in Papillary Thyroid Cancer: Upregulation of LINC00887 Promotes Cell Proliferation, Growth and Invasion. International Journal of Molecular Sciences. 2024; 25(3):1587. https://doi.org/10.3390/ijms25031587
Chicago/Turabian StyleTous, Cristina, Carmen Muñoz-Redondo, Angela Gavilán, Nereida Bravo-Gil, Fátima Baco-Antón, Elena Navarro-González, Guillermo Antiñolo, and Salud Borrego. 2024. "Delving into the Role of lncRNAs in Papillary Thyroid Cancer: Upregulation of LINC00887 Promotes Cell Proliferation, Growth and Invasion" International Journal of Molecular Sciences 25, no. 3: 1587. https://doi.org/10.3390/ijms25031587
APA StyleTous, C., Muñoz-Redondo, C., Gavilán, A., Bravo-Gil, N., Baco-Antón, F., Navarro-González, E., Antiñolo, G., & Borrego, S. (2024). Delving into the Role of lncRNAs in Papillary Thyroid Cancer: Upregulation of LINC00887 Promotes Cell Proliferation, Growth and Invasion. International Journal of Molecular Sciences, 25(3), 1587. https://doi.org/10.3390/ijms25031587
